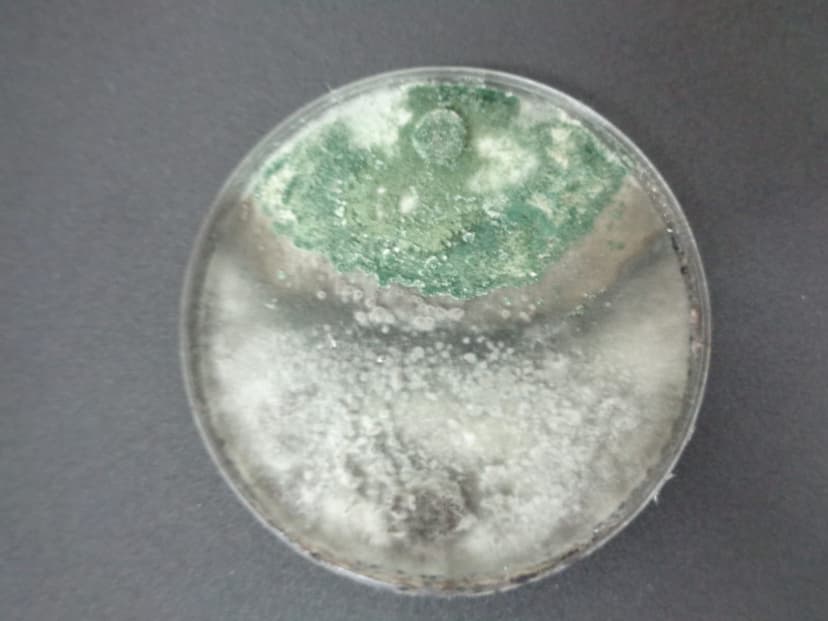
Colonia de Trichoderma

Metodos de Control Fungal
Guias tecnicas e informacion especializada sobre estrategias de manejo integrado de hongos fitopatogenos en agricultura.

Manejo Integrado de Enfermedades
Tres enfoques complementarios para el control efectivo de hongos fitopatogenos como Colletotrichum spp.
Recomendado Control Biologico
El uso de Trichoderma spp. como agente de biocontrol representa una alternativa sostenible y efectiva contra la antracnosis. Este hongo benefico actua mediante multiples mecanismos: micoparasitismo directo, competencia por espacio y nutrientes, antibiosis y estimulacion de las defensas naturales de la planta.
Micoparasitismo
Trichoderma enrolla sus hifas alrededor del patogeno, secreta enzimas liticas (quitinasas, glucanasas) y degrada la pared celular de Colletotrichum.
Competencia
Por su rapido crecimiento y alta capacidad de esporulacion, Trichoderma coloniza rapidamente el sustrato, excluyendo al patogeno de fuentes nutricionales y espacios de colonizacion.
Antibiosis
Produccion de metabolitos volatiles y no volatiles con actividad antifungica, incluyendo peptaiboles, trichodermina y viridina, que inhiben el crecimiento del patogeno.
Induccion de Resistencia
Trichoderma estimula los mecanismos de defensa de la planta (SAR e ISR), aumentando la produccion de fitoalexinas, proteinas PR y refuerzo de la pared celular.
Complementario Control Quimico
El control quimico mediante fungicidas sigue siendo una herramienta importante dentro del manejo integrado. Sin embargo, debe utilizarse de forma racional, alternando ingredientes activos para evitar resistencia.
Fungicidas Sistemicos
Son absorbidos y translocados dentro de la planta, protegiendo tejidos nuevos. Incluyen estrobilurinas, triazoles y carboxamidas. Efectivos como preventivos y curativos tempranos.
Fungicidas de Contacto
Permanecen en la superficie de la planta formando una barrera protectora. Incluyen mancozeb, clorotalonil y oxicloruro de cobre. Requieren aplicaciones frecuentes.
Prevencion Control Cultural
Practicas agronomicas que reducen las condiciones favorables para el desarrollo del patogeno y minimizan las fuentes de inoculo en el cultivo.
Podas Sanitarias
Eliminacion sistematica de ramas, hojas y frutos infectados para reducir las fuentes de inoculo. Las herramientas deben desinfectarse entre cortes con hipoclorito de sodio al 2%.
Manejo de Residuos
Destruccion o compostaje de residuos vegetales infectados. Evitar acumulacion de material enfermo en la parcela. Solarizacion del suelo en periodos de descanso.
Comparacion de Metodos
| Criterio | Control Biologico | Control Quimico | Control Cultural |
|---|---|---|---|
| Eficacia | 70-85% | 85-95% | 50-70% |
| Impacto ambiental | Minimo | Alto | Minimo |
| Resistencia | No genera | Alto riesgo | No aplica |
| Costo | Medio | Alto | Bajo |
| Persistencia | Autosostenible | Temporal | Permanente |
| Seguridad alimentaria | Excelente | Residuos | Excelente |